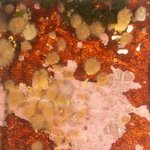
IMG_0027.jpg

Use the Browse Images, Edit Metadata, and Browse Patches pages to get an overview of your source's images, and manage/process those images in various ways.
Browse Images
Browse through pages of images displayed as thumbnails. Below the grid, click the arrow buttons to go to the next or previous page.
The search box at the top lets you choose a subset of images. Change the search fields, then click Search to apply the filters. Some tips:
- The "Sort by" and "Direction" fields let you change the ordering of the search results.
- The "Image name contains" field accepts punctuation, and accepts multiple search terms separated by spaces. So you can use search queries like .jpg dsc_ or dupe-name.
-
If some of your images have values filled in for the auxiliary metadata fields, those metadata fields will appear on the search form. This will typically appear as a dropdown field, but it will be a text-input field if the source has a large number of unique values for that field.
- If it's a text-input field, click the ... button next to the field for more details.
You can mouse-over an image thumbnail to see its filename and annotation status. The thumbnail's border color also indicates the image's annotation status.
The "Image Actions" box below the page navigator lets you run an action on the current set of images. (You must be signed in to see the box.) Select an action with the left dropdown, then use the right dropdown to specify whether to apply the action to all images in the search, or just the images on this page. Depending on the action, additional explanations and options may appear as well. Click "Go" to run the action.
Edit Metadata
Requires source Edit or Admin permissions.
Show images' metadata as a grid of text fields. When there are many images in the grid, this page can get very slow to respond, so make sure to use the search form to narrow down the image results to a manageable size.
Type in the text fields to edit the metadata, then click the Save Edits button below to save your edits. If there are any errors, the errors will display below the metadata grid and nothing will be saved yet. Note that saving might take a while if there are many images in the metadata grid.
You can edit multiple images' metadata at the same time by using the checkboxes along the left side. If you check multiple images, and then edit the metadata of one of those checked images, those edits will be applied to all of the images you've checked. You can also use the top checkbox to check or un-check all of the images.
The "Height (cm)" field is the number of centimeters of substrate the image covers, from the top of the image to the bottom. This was formerly required by the automatic annotation system, but now it's just an ordinary metadata field that you can optionally fill in for your information.
Browse Patches
Similar to Browse Images, except that each thumbnail is an image cut-out or "patch" which represents a point location within that image. You can use the Search form to only display patches of a particular Label. Mouse-over an image patch to see which image and which point the patch is from.
If the search contains a very high number of annotations, it can be slow to count all the results, so we limit the result count if it's too high. The pagination text will show something like "Showing 1-20 out of 20000 or more" if this is the case.